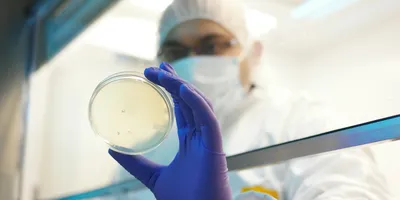
Environmental monitoring in pharma using a settle plate

In sterile drug manufacturing, the reliability of environmental monitoring and sterility testing is closely tied to the tools used to conduct them. Every time these materials are introduced into cleanrooms, isolators, or restricted access barrier systems (RABS), they can inadvertently introduce contamination, triggering lengthy investigations, production delays, and financial losses.
This infographic provides a framework for selecting media and sampling tools that preserve sterility and align with regulatory standards. It details the functional requirements for various monitoring sites, identifies how microorganisms dictate media choice, and outlines how specialized packaging configurations support aseptic entry and handling. Together, these considerations help teams reduce cross-contamination risk, strengthen compliance, and support consistent, defensible results across their operations.
Download the Environmental Monitoring and Sterility Testing infographic to explore:
- Criteria for selecting sampling tools based on the environment being tested
- Packaging and transport solutions that support aseptic entry and handling within cleanroom, isolators, and RABS
- Media selection and incubation considerations that align with sterility testing requirements
- Key features to look for when selecting sampling tools and prepared bottled media